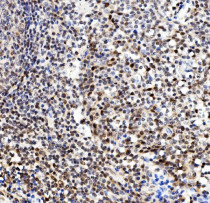

ARG43135
anti-FOXK1 / MNF antibody
anti-FOXK1 / MNF antibody for Flow cytometry,ICC/IF,IHC-Formalin-fixed paraffin-embedded sections,Western blot and Human,Mouse,Rat
概述
| 产品描述 | Rabbit Polyclonal antibody recognizes FOXK1 / MNF |
|---|---|
| 反应物种 | Hu, Ms, Rat |
| 应用 | FACS, ICC/IF, IHC-P, WB |
| 宿主 | Rabbit |
| 克隆 | Polyclonal |
| 同位型 | IgG |
| 靶点名称 | FOXK1 / MNF |
| 抗原物种 | Human |
| 抗原 | Recombinant protein corresponding to Q175-E671 of Human FOXK1 / MNF. |
| 偶联标记 | Un-conjugated |
| 別名 | Myocyte nuclear factor; FOXK1L; MNF; Forkhead box protein K1 |
应用说明
| 应用建议 |
|
||||||||||
|---|---|---|---|---|---|---|---|---|---|---|---|
| 应用说明 | IHC-P: Antigen Retrieval: Heat mediation was performed in EDTA buffer (pH 8.0). * The dilutions indicate recommended starting dilutions and the optimal dilutions or concentrations should be determined by the scientist. |
||||||||||
| 实际分子量 | ~ 95 kDa |
属性
| 形式 | Liquid |
|---|---|
| 纯化 | Immunogen affinity purified. |
| 缓冲液 | 0.2% Na2HPO4, 0.9% NaCl, 0.05% Sodium azide and 4% Trehalose. |
| 抗菌剂 | 0.05% Sodium azide |
| 稳定剂 | 4% Trehalose |
| 浓度 | 0.5 mg/ml |
| 存放说明 | For continuous use, store undiluted antibody at 2-8°C for up to a week. For long-term storage, aliquot and store at -20°C or below. Storage in frost free freezers is not recommended. Avoid repeated freeze/thaw cycles. Suggest spin the vial prior to opening. The antibody solution should be gently mixed before use. |
| 注意事项 | For laboratory research only, not for drug, diagnostic or other use. |
生物信息
| 数据库连接 | |
|---|---|
| 基因名称 | FOXK1 |
| 全名 | forkhead box K1 |
| 生物功能 | Transcriptional regulator involved in different processes such as glucose metabolism, aerobic glycolysis, muscle cell differentiation and autophagy (By similarity). Recognizes and binds the forkhead DNA sequence motif (5'-GTAAACA-3') and can both act as a transcription activator or repressor, depending on the context (PubMed:17670796). Together with FOXK2, acts as a key regulator of metabolic reprogramming towards aerobic glycolysis, a process in which glucose is converted to lactate in the presence of oxygen (By similarity). Acts by promoting expression of enzymes for glycolysis (such as hexokinase-2 (HK2), phosphofructokinase, pyruvate kinase (PKLR) and lactate dehydrogenase), while suppressing further oxidation of pyruvate in the mitochondria by up-regulating pyruvate dehydrogenase kinases PDK1 and PDK4 (By similarity). Probably plays a role in gluconeogenesis during overnight fasting, when lactate from white adipose tissue and muscle is the main substrate (By similarity). Involved in mTORC1-mediated metabolic reprogramming: in response to mTORC1 signaling, translocates into the nucleus and regulates the expression of genes associated with glycolysis and downstream anabolic pathways, such as HIF1A, thereby regulating glucose metabolism (By similarity). Together with FOXK2, acts as a negative regulator of autophagy in skeletal muscle: in response to starvation, enters the nucleus, binds the promoters of autophagy genes and represses their expression, preventing proteolysis of skeletal muscle proteins (By similarity). Acts as a transcriptional regulator of the myogenic progenitor cell population in skeletal muscle (By similarity). Binds to the upstream enhancer region (CCAC box) of myoglobin (MB) gene, regulating the myogenic progenitor cell population (By similarity). Promotes muscle progenitor cell proliferation by repressing the transcriptional activity of FOXO4, thereby inhibiting myogenic differentiation (By similarity). Involved in remodeling processes of adult muscles that occur in response to physiological stimuli (By similarity). Required to correct temporal orchestration of molecular and cellular events necessary for muscle repair (By similarity). Represses myogenic differentiation by inhibiting MEFC activity (By similarity). Positively regulates Wnt/beta-catenin signaling by translocating DVL into the nucleus (PubMed:25805136). Reduces virus replication, probably by binding the interferon stimulated response element (ISRE) to promote antiviral gene expression (PubMed:25852164). [UniProt] |
| 细胞定位 | Nucleus. Cytoplasm. Note=(Microbial infection) Accumulates in the nucleus upon viral infection. [UniProt] |
| 预测分子量 | 75 kDa |
检测图片 (6) Click the Picture to Zoom In
-
ARG43135 anti-FOXK1 / MNF antibody ICC/IF image
Immunofluorescence: Human ovary cancer cells were blocked with 10% goat serum and then stained with ARG43135 anti-FOXK1 / MNF antibody (green) at 2 µg/ml dilution, overnight at 4°C.
-
ARG43135 anti-FOXK1 / MNF antibody IHC-P image
Immunohistochemistry: Paraffin-embedded Human lung cancer tissue. Antigen Retrieval: Heat mediation was performed in EDTA buffer (pH 8.0). The tissue section was blocked with 10% goat serum. The tissue section was then stained with ARG43135 anti-FOXK1 / MNF antibody at 1 µg/ml dilution, overnight at 4°C.
-
ARG43135 anti-FOXK1 / MNF antibody WB image
Western blot: 50 µg of sample under reducing conditions. K562, U2OS, HeLa, T-47D, Caco-2, Rat brain and SP20 cell lysates stained with ARG43135 anti-FOXK1 / MNF antibody at 0.25 µg/ml dilution, overnight at 4°C.
-
ARG43135 anti-FOXK1 / MNF antibody FACS image
Flow Cytometry: THP-1 cells were blocked with 10% normal goat serum and then stained with ARG43135 anti-FOXK1 / MNF antibody (blue) at 1 µg/10^6 cells for 30 min at 20°C, followed by incubation with DyLight®488 labelled secondary antibody. Isotype control antibody (green) was rabbit IgG (1 µg/10^6 cells) used under the same conditions. Unlabelled sample (red) was also used as a control.
-
ARG43135 anti-FOXK1 / MNF antibody ICC/IF image
Immunofluorescence: A549 cells were blocked with 10% goat serum and then stained with ARG43135 anti-FOXK1 / MNF antibody (green) at 2 µg/ml dilution, overnight at 4°C. DAPI (blue) for nuclear staining.
-
ARG43135 anti-FOXK1 / MNF antibody IHC-P image
Immunohistochemistry: Paraffin-embedded Human tonsil tissue. Antigen Retrieval: Heat mediation was performed in EDTA buffer (pH 8.0). The tissue section was blocked with 10% goat serum. The tissue section was then stained with ARG43135 anti-FOXK1 / MNF antibody at 1 µg/ml dilution, overnight at 4°C.